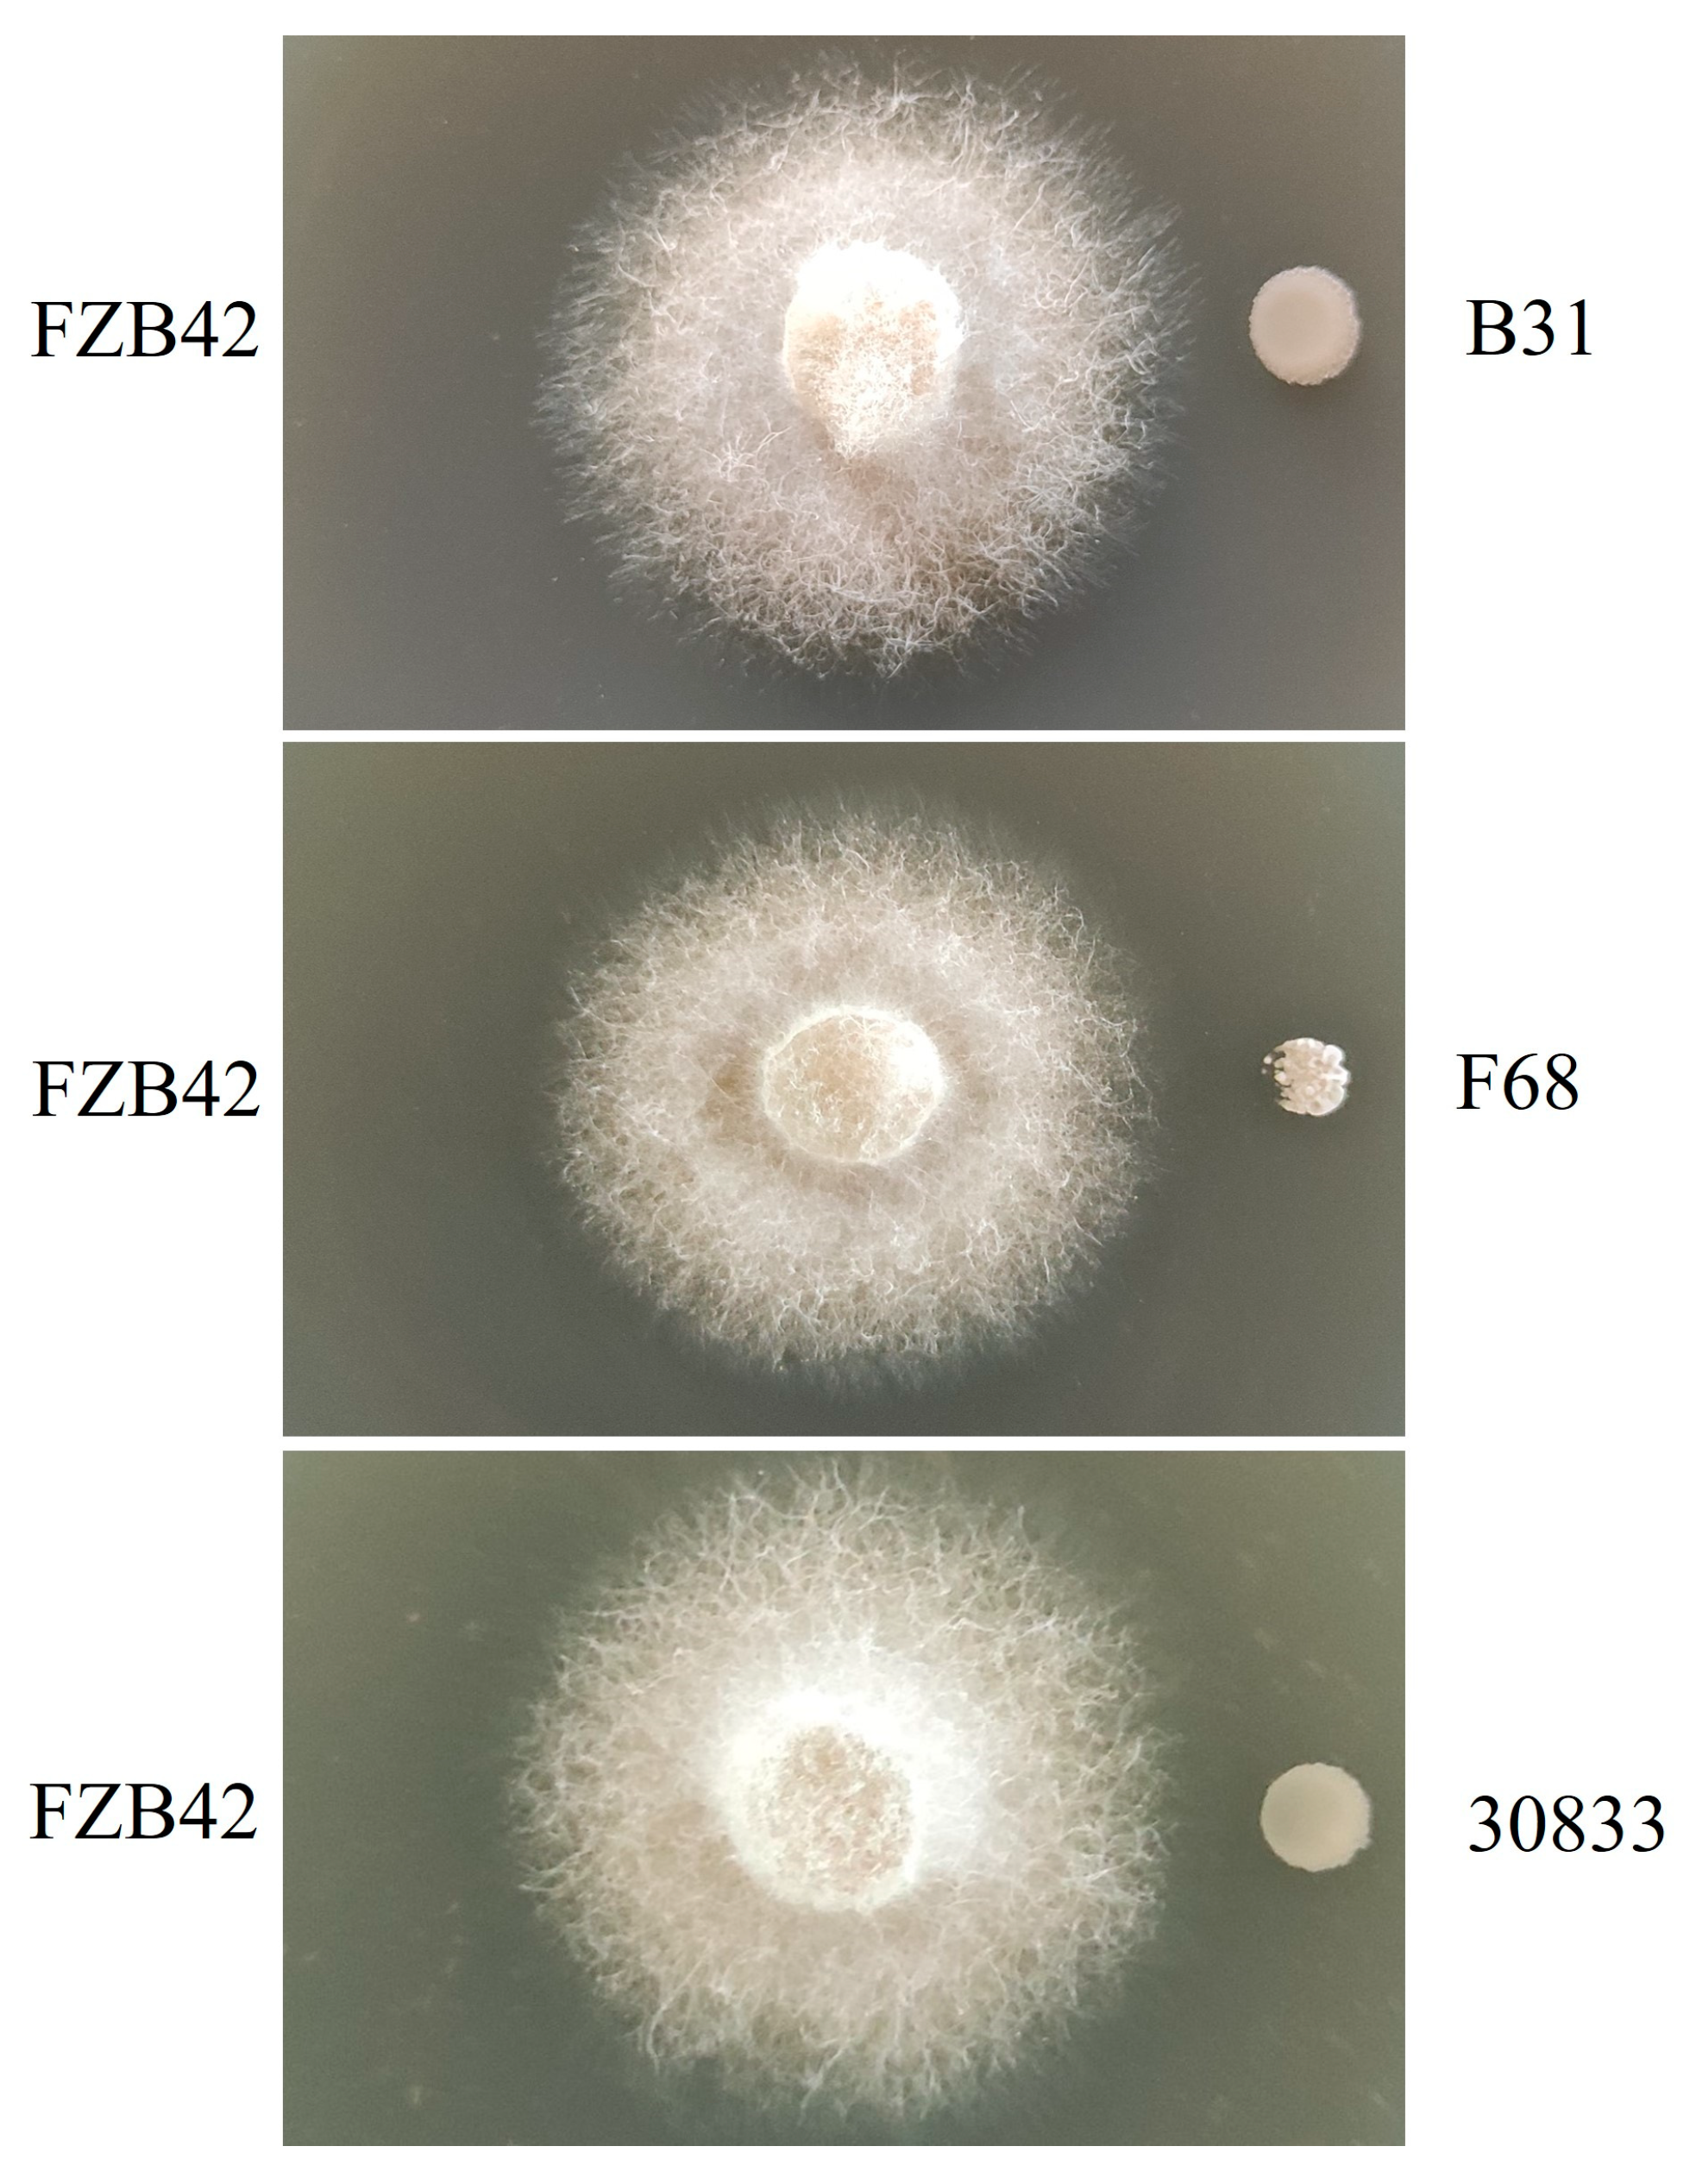
Toxins 15 00381 g002 Toxins 15 00381 g002

Screening Biocontrol Agents for Cash Crop Fusarium Wilt Based on Fusaric Acid Tolerance and Antagonistic Activity against Fusarium oxysporum
Abstract
1. Introduction
2. Results
2.1. Screening of Bacteria with Tolerance to FA and Antagonistic Abilities against Foc
2.2. Screening of Biocontrol Agents against Cucumber Fusarium Wilt
2.3. Biocontrol Effects of Biocontrol Agents on Fusarium Wilt of Tomato and Watermelon
2.4. Identification of Strains B31, F68, and 30833
2.5. Strains B31, F68, and 30833 Increased Tolerance to the Inhibitory Effect of Foc
2.6. Strains B31, F68, and 30833 Showed Increased Tolerance to Foc Metabolites
2.7. Tolerance of Strains B31, 30833, and F68 to FA
3. Discussion
4. Conclusions
5. Materials and Methods
5.1. Screening of Bacillus Strains with FA Tolerance
5.2. Antifungal Activity of Bacillus
5.3. Determination of the Control Effect of Bacillus on Cucumber Wilt, Tomato Wilt, and Watermelon Wilt
5.4. Identification of Biocontrol Agents
5.5. Antagonistic Ability of Fusarium Oxysporum against the Growth of Bacillus Strains
5.6. Inhibitory Ability of Foc Fermentation against the Growth of Biocontrol Bacteria
5.7. Tolerance of Biocontrol Bacteria to FA
5.8. Statistical Analysis
Supplementary Materials
Author Contributions
Funding
Institutional Review Board Statement
Informed Consent Statement
Data Availability Statement
Conflicts of Interest
References
- Jeon, B.; Kang, J.; Park, M.; Kim, B. Antifungal activity of streptavidin C1 and C2 against pathogens causing Fusarium wilt. Lett. Appl. Microbiol. 2021, 73, 453–459. [Google Scholar] [CrossRef] [PubMed]
- Pal, S.; Rao, E.S.; Hebbar, S.S.; Sriram, S.; Pitchaimuthu, M.; Rao, V.K. Assessment of Fusarium wilt resistant Citrullus sp. rootstocks for yield and quality traits of grafted watermelon. Sci. Hortic. 2020, 272, 109497. [Google Scholar] [CrossRef]
- Kamel, S.; Taher, D.I. Grafting cucumber onto interspecific cucurbita hybrid rootstocks to improve productivity and control wilt disease caused by Fusarium oxysporum f. sp. cucumerinum. J. Plant Prod. 2021, 12, 41–47. [Google Scholar] [CrossRef]
- Minuto, A.; Spadaro, D.; Garibaldi, A.; Gullino, M.L. Control of soilborne pathogens of tomato using a commercial formulation of Streptomyces griseoviridis and solarization. Crop Prot. 2006, 25, 468–475. [Google Scholar] [CrossRef]
- Khalifa, M.W.; Rouag, N.; Bouhadida, M. Evaluation of the antagonistic effect of Pseudomonas rhizobacteria on Fusarium wilt of chickpea. Agriculture 2022, 12, 429. [Google Scholar] [CrossRef]
- Mozumder, A.B.; Chanda, K.; Chorei, R.; Prasad, H.K. An evaluation of aluminum tolerant Pseudomonas aeruginosa A7 for in vivo suppression of Fusarium wilt of chickpea caused by Fusarium oxysporum f. sp. ciceris and growth promotion of chickpea. Microorganisms 2022, 10, 568. [Google Scholar] [CrossRef]
- Awad-Allah, E.F.; Shams, A.H.; Helaly, A.A.; Ragheb, E.I. Effective applications of Trichoderma spp. as biofertilizers and biocontrol agents mitigate tomato Fusarium wilt disease. Agriculture 2022, 12, 1950. [Google Scholar] [CrossRef]
- Do Amaral, A.C.T.; De Holanda Cavalcanti Maciel, M.; Machado, A.R.; De Oliveira, L.G.; Lima, C.S.; Da Costa, A.F.; De Oliveira, N.T. Trichoderma as a biological agent of Fusarium oxysporum species complex and Vigna unguiculata growth promoter. Eur. J. Plant Pathol. 2022, 163, 875–890. [Google Scholar] [CrossRef]
- Rao, Y.; Zeng, L.; Jiang, H.; Mei, L.; Wang, Y. Trichoderma atroviride LZ42 releases volatile organic compounds promoting plant growth and suppressing Fusarium wilt disease in tomato seedlings. BMC Microbiol. 2022, 22, 88. [Google Scholar] [CrossRef]
- Cao, Y.; Zhang, Z.; Ling, N.; Yuan, Y.; Zheng, X.; Shen, B.; Shen, Q. Bacillus subtilis SQR 9 can control Fusarium wilt in cucumber by colonizing plant roots. Biol. Fertil. Soils 2011, 47, 495–506. [Google Scholar] [CrossRef]
- Medeiros, C.; Bettiol, W. Multifaceted intervention of Bacillus spp. against salinity stress and Fusarium wilt in tomato. J. Appl. Microbiol. 2021, 131, 2387–2401. [Google Scholar] [CrossRef]
- Haddoudi, I.; Cabrefiga, J.; Mora, I.; Mhadhbi, H.; Montesinos, E.; Mrabet, M. Biological control of Fusarium wilt caused by Fusarium equiseti in Vicia faba with broad spectrum antifungal plant-associated Bacillus spp. Biol. Control 2021, 160, 104671. [Google Scholar] [CrossRef]
- Moreno-Velandia, C.A.; Ongena, M.; Cotes, A.M. Effects of fengycins and iturins on Fusarium oxysporum f. sp. physali and root colonization by Bacillus velezensis Bs006 protect golden berry against vascular wilt. Phytopathology 2021, 111, 2227–2237. [Google Scholar] [CrossRef] [PubMed]
- Sharma, A.; Kaushik, N.; Sharma, A.; Bajaj, A.; Rasane, M.; Shouche, Y.S.; Marzouk, T.; Djébali, N. Screening of tomato seed bacterial endophytes for antifungal activity reveals lipopeptide producing Bacillus siamensis strain NKIT9 as a potential bio-control agent. Front. Microbiol. 2021, 12, 609482. [Google Scholar] [CrossRef] [PubMed]
- Zhang, Q.; Stummer, B.E.; Guo, Q.; Zhang, W.; Zhang, X.; Zhang, L.; Harvey, P.R. Quantification of Pseudomonas protegens FD6 and Bacillus subtilis NCD-2 in soil and the wheat rhizosphere and suppression of root pathogenic Rhizoctonia solani AG-8. Biol. Control 2021, 154, 104504. [Google Scholar] [CrossRef]
- Yánez-Mendizábal, V.; Falconí, C.E. Bacillus subtilis CtpxS2-1 induces systemic resistance against anthracnose in Andean lupin by lipopeptide production. Biotechnol. Lett. 2021, 43, 719–728. [Google Scholar] [CrossRef]
- Bathke, K.J.; Jochum, C.C.; Yuen, G.Y. Biological control of bacterial leaf streak of corn using systemic resistance-inducing Bacillus strains. Crop Prot. 2022, 155, 105932. [Google Scholar] [CrossRef]
- Weng, J.; Wang, Y.; Li, J.; Shen, Q.; Zhang, R. Enhanced root colonization and biocontrol activity of Bacillus amyloliquefaciens SQR9 by abrB gene disruption. Appl. Microbiol. Biotechnol. 2013, 97, 8823–8830. [Google Scholar] [CrossRef]
- Lakshmanan, V.; Bais, H.P. Factors other than root secreted malic acid that contributes toward Bacillus subtilis FB17 colonization on Arabidopsis roots. Plant Signal. Behav. 2013, 8, 657–668. [Google Scholar] [CrossRef]
- Arumugam, T.; Ghazi, T.; Abdul, N.S.; Chuturgoon, A.A. A review on the oxidative effects of the fusariotoxins: Fumonisin B1 and fusaric acid. In Toxicology; Academic Press: Cambridge, MA, USA, 2021; pp. 181–190. [Google Scholar]
- Iqbal, N.; Czékus, Z.; Ördög, A.; Poór, P. Ethylene-dependent effects of fusaric acid on the photosynthetic activity of tomato plants. Photosynthetica 2021, 59, 337–348. [Google Scholar] [CrossRef]
- Thanh, T.T.; Quoc, T.N.; Xuan, H.L. Fusaric acid and derivatives as novel antimicrobial agents. Med. Chem. Res. 2020, 29, 1689–1696. [Google Scholar] [CrossRef]
- Raza, W.; Yuan, J.; Wu, Y.; Rajer, F.; Huang, Q.; Qirong, S. Biocontrol traits of two Paenibacillus polymyxa strains SQR-21 and WR-2 in response to fusaric acid, a phytotoxin produced by Fusarium species. Plant Pathol. 2015, 64, 1041–1052. [Google Scholar] [CrossRef]
- Van Rij, E.T.; Girard, G.; Lugtenberg, B.J.; Bloemberg, G.V. Influence of fusaric acid on phenazine-1-carboxamide synthesis and gene expression of Pseudomonas chlororaphis strain PCL1391. Microbiology 2005, 151, 2805–2814. [Google Scholar] [CrossRef]
- Schnider-Keel, U.; Seematter, A.; Maurhofer, M.; Blumer, C.; Duffy, B.; Gigot-Bonnefoy, C.C.; Reimmann, C.; Notz, R.; DeéFago, G.V.; Haas, D. Autoinduction of 2, 4-diacetylphloroglucinol biosynthesis in the biocontrol agent Pseudomonas fluorescens CHA0 and repression by the bacterial metabolites salicylate and pyoluteorin. J. Bacteriol. 2000, 182, 1215–1225. [Google Scholar] [CrossRef] [PubMed]
- Utsumi, R.; Hadama, T.; Noda, M.; Toyoda, H.; Hashimoto, H.; Ohuchi, S. Cloning of fusaric acid-detoxifying gene from Cladosporium werneckii: A new strategy for the prevention of plant diseases. J. Biotechnol. 1988, 8, 311–316. [Google Scholar] [CrossRef]
- Simonetti, E.; Roberts, I.N.; Montecchia, M.S.; Gutierrez-Boem, F.H.; Gomez, F.M.; Ruiz, J.A. A novel Burkholderia ambifaria strain able to degrade the mycotoxin fusaric acid and to inhibit Fusarium spp. growth. Microbiol. Res. 2018, 206, 50–59. [Google Scholar] [CrossRef]
- Bai, M.; Zheng, G. A method for determination of resistance to tomato Fusarium wilt in greenhouse. ACTA Phytopathol. Sin. 1997, 27, 59–63. [Google Scholar]
- Hong, H.A.; To, E.; Fakhry, S.; Baccigalupi, L.; Ricca, E.; Cutting, S.M. Defining the natural habitat of Bacillus spore-formers. Res. Microbiol. 2009, 160, 375–379. [Google Scholar] [CrossRef]
- Guo, Q.; Dong, W.; Li, S.; Lu, X.; Wang, P.; Zhang, X.; Wang, Y.; Ma, P. Fengycin produced by Bacillus subtilis NCD-2 plays a major role in biocontrol of cotton seedling damping-off disease. Microbiol. Res. 2014, 169, 533–540. [Google Scholar] [CrossRef]
- Dong, L.H.; Guo, Q.G.; Zhang, X.Y.; Li, S.Z.; Lu, X.Y.; Ma, P. Effects of cotton root exudates on the biofilm formation and root colonization of Bacillus subtilis strain NCD-2. Acta Phytopathol. Sin. 2015, 45, 541–547. [Google Scholar]
- Kavitha, T.; Suneetha, C.; Sunitha, T. Heat-treatment method for isolation of Bacillus spp. from plant tissues. In Endophytic Microbes: Isolation, Identification, and Bioactive Potentials; Springer: Berlin/Heidelberg, Germany, 2022; pp. 7–13. [Google Scholar]
- Haichar, F.E.Z.; Marol, C.; Berge, O.; Rangel-Castro, J.I.; Prosser, J.I.; Balesdent, J.; Heulin, T.; Achouak, W. Plant host habitat and root exudates shape soil bacterial community structure. ISME J. 2008, 2, 1221–1230. [Google Scholar] [CrossRef] [PubMed]
- Maryani, N.; Lombard, L.; Poerba, Y.; Subandiyah, S.; Crous, P.; Kema, G. Phylogeny and genetic diversity of the banana Fusarium wilt pathogen Fusarium oxysporum f. sp. cubense in the Indonesian centre of origin. Stud. Mycol. 2019, 92, 155–194. [Google Scholar] [CrossRef] [PubMed]
- Toyoda, H.; Katsuragi, K.; Tamai, T.; Ouchi, S. DNA sequence of genes for detoxification of fusaric acid, a wilt-inducing agent produced by Fusarium species. J. Phytopathol. 1991, 133, 265–277. [Google Scholar] [CrossRef]
- Thangavelu, R.; Palaniswami, A.; Ramakrishnan, G.; Doraiswamy, S.; Muthukrishnan, S.; Velazhahan, R. Involvement of fusaric acid detoxification by Pseudomonas fluorescens strain Pf10 in the biological control of Fusarium wilt of banana caused by Fusarium oxysporum f. sp. cubense/Detoxifikation der Fusarinsäure durch Stamm Pf10 von Pseudomonas fluorescens als eine Komponente bei der biologischen Bekämpfung der durch Fusarium oxysporum f. sp. cubens verursachten Bananenwelke. Z. Pflanzenkrankh. Pflanzenschutz J. Plant Dis. Prot. 2001, 108, 433–445. [Google Scholar]
- Bacon, C.; Hinton, D.; Porter, J.; Glenn, A.; Kuldau, G. Fusaric acid, a Fusarium verticillioides metabolite, antagonistic to the endophytic biocontrol bacterium Bacillus mojavensis. Can. J. Bot. 2004, 82, 878–885. [Google Scholar] [CrossRef]
- Song, Y.; Xu, G.; Li, C.; Li, Z.; Lu, C.; Shen, Y. Structural optimization of natural product fusaric acid to discover novel T3SS inhibitors of Salmonella. Biochem. Biophys. Res. Commun. 2021, 582, 72–76. [Google Scholar] [CrossRef]
- Portal Gonzalez, N.; Soler, A.; Ribadeneira, C.; Solano, J.; Portieles, R.; Herrera Isla, L.; Companioni, B.; Borras-Hidalgo, O.; Santos Bermudez, R. Phytotoxic metabolites produce by Fusarium oxysporum f. sp. cubense Race 2. Front. Microbiol. 2021, 12, 629395. [Google Scholar] [CrossRef]
- Hu, R.-M.; Liao, S.-T.; Huang, C.-C.; Huang, Y.-W.; Yang, T.-C. An inducible fusaric acid tripartite efflux pump contributes to the fusaric acid resistance in Stenotrophomonas maltophilia. PLoS ONE 2012, 7, e51053. [Google Scholar] [CrossRef]
- Utsumi, R.; Yagi, T.; Katayama, S.; Katsuragi, K.; Tachibana, K.; Toyoda, H.; Ouchi, S.; Obata, K.; Shibano, Y.; Noda, M. Molecular cloning and characterization of the fusaric acid-resistance gene from Pseudomonas cepacia. Agric. Biol. Chem. 1991, 55, 1913–1918. [Google Scholar] [CrossRef]
- Rooney, A.P.; Price, N.P.; Ehrhardt, C.; Swezey, J.L.; Bannan, J.D. Phylogeny and molecular taxonomy of the Bacillus subtilis species complex and description of Bacillus subtilis subsp. inaquosorum subsp. nov. Int. J. Syst. Evol. Microbiol. 2009, 59, 2429–2436. [Google Scholar] [CrossRef]
- Ruiz, J.A.; Bernar, E.M.; Jung, K. Production of siderophores increases resistance to fusaric acid in Pseudomonas protegens Pf-5. PLoS ONE 2015, 10, e0117040. [Google Scholar] [CrossRef] [PubMed]
- Zhuang, J.; Gao, Z.; Yang, C.; Chen, J.; Xue, C.; Mu, C. Biocontrol of Fusarium wilt and induction of defense enzyme activities on cucumber by Trichoderma viride strain T23. Acta Phytopathol. Sin. 2005, 35, 179–183. [Google Scholar]
- Yu, G.; Niu, C.; Chen, Y.; Chen, Y.; Yang, Z. Use of 16S rDNA, gyrA and gyrB gene sequence to identify a biocontrol Bacillus sp. strain R31. Chin. J. Biol. Control. 2010, 26, 160–166. [Google Scholar]
- Guo, Q.; Li, S.; Lu, X.; Li, B.; Stummer, B.; Dong, W.; Ma, P. phoR sequences as a phylogenetic marker to differentiate the species in the Bacillus subtilis group. Can. J. Microbiol. 2012, 58, 1295–1305. [Google Scholar] [CrossRef] [PubMed]
- Larkin, M.A.; Blackshields, G.; Brown, N.P.; Chenna, R.; Mcgettigan, P.A.; Mcwilliam, H.; Valentin, F.; Wallace, I.M.; Wilm, A.; Lopez, R. Clustal W and Clustal X version 2.0. Bioinformatics 2007, 23, 2947–2948. [Google Scholar] [CrossRef]
- Tamura, K.; Dudley, J.; Nei, M.; Kumar, S. MEGA4: Molecular evolutionary genetics analysis (MEGA) software version 4.0. Mol. Biol. Evol. 2007, 24, 1596–1599. [Google Scholar] [CrossRef]
- St-Arnaud, M.; Hamel, C.; Vimard, B.; Caron, M.; Fortin, J. Altered growth of Fusarium oxysporum f. sp. chrysanthemi in an in vitro dual culture system with the vesicular arbuscular mycorrhizal fungus Glomus intraradices growing on Daucus carota transformed roots. Mycorrhiza 1995, 5, 431–438. [Google Scholar] [CrossRef]

| Strain | Biocontrol Efficacy (%) | ||
|---|---|---|---|
| Cucumber Fusarium Wilt | Tomato Fusarium Wilt | Watermelon Fusarium Wilt | |
| B31 | 97.12 ± 0 a | 85.72 ± 10.10 a | 84.26 ± 10.63 a |
| 30833 | 88.02 ± 2.72 ab | 85.72 ± 20.20 a | 65.22 ± 7.68 a |
| F68 | 74.04 ± 8.16 bc | 83.33 ± 13.68 a | 64.13 ± 2.66 a |
| F38 | 82.69 ± 7.07 ab | 83.33 ± 23.57 a | 61.96 ± 7.04 a |
| A84 | 61.54 ± 7.57 c | 71.43 ± 15.71 a | 27.80 ± 15.43 b |
Disclaimer/Publisher’s Note: The statements, opinions and data contained in all publications are solely those of the individual author(s) and contributor(s) and not of MDPI and/or the editor(s). MDPI and/or the editor(s) disclaim responsibility for any injury to people or property resulting from any ideas, methods, instructions or products referred to in the content. |
© 2023 by the authors. Licensee MDPI, Basel, Switzerland. This article is an open access article distributed under the terms and conditions of the Creative Commons Attribution (CC BY) license (https://creativecommons.org/licenses/by/4.0/).
Share and Cite
Guo, Q.; Li, S.; Dong, L.; Su, Z.; Wang, P.; Liu, X.; Ma, P. Screening Biocontrol Agents for Cash Crop Fusarium Wilt Based on Fusaric Acid Tolerance and Antagonistic Activity against Fusarium oxysporum. Toxins 2023, 15, 381. https://doi.org/10.3390/toxins15060381
Guo Q, Li S, Dong L, Su Z, Wang P, Liu X, Ma P. Screening Biocontrol Agents for Cash Crop Fusarium Wilt Based on Fusaric Acid Tolerance and Antagonistic Activity against Fusarium oxysporum. Toxins. 2023; 15(6):381. https://doi.org/10.3390/toxins15060381
Chicago/Turabian StyleGuo, Qinggang, Shixin Li, Lihong Dong, Zhenhe Su, Peipei Wang, Xiaomeng Liu, and Ping Ma. 2023. "Screening Biocontrol Agents for Cash Crop Fusarium Wilt Based on Fusaric Acid Tolerance and Antagonistic Activity against Fusarium oxysporum" Toxins 15, no. 6: 381. https://doi.org/10.3390/toxins15060381
APA StyleGuo, Q., Li, S., Dong, L., Su, Z., Wang, P., Liu, X., & Ma, P. (2023). Screening Biocontrol Agents for Cash Crop Fusarium Wilt Based on Fusaric Acid Tolerance and Antagonistic Activity against Fusarium oxysporum. Toxins, 15(6), 381. https://doi.org/10.3390/toxins15060381




